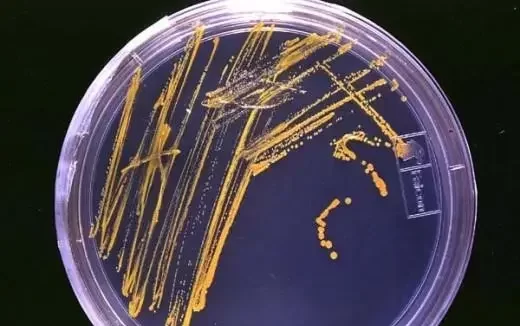
The Manufacturing Process and Equipment Requirements for Powdered Culture Media
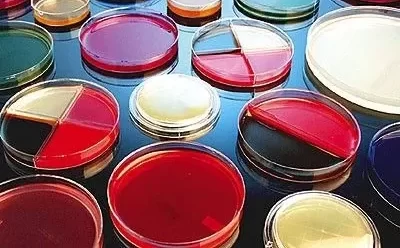
Introduction to Infusion Powders Used in Culture Media
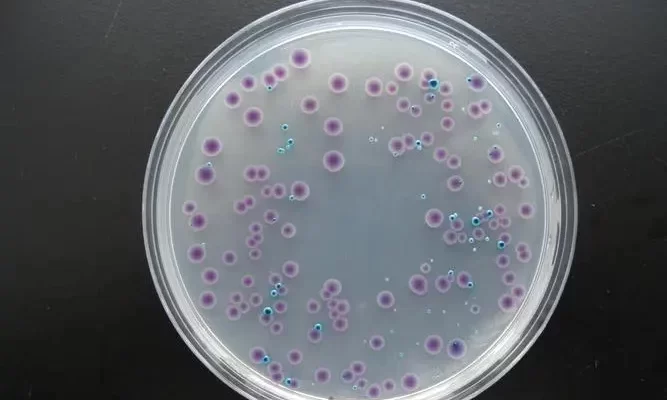
About Microbial Culture Media: Top 10 Questions and Answers

The Manufacturing Process and Equipment Requirements for Powdered Culture Media
News 9 10 月, 2024
Powdered culture media are essential components in microbiology laboratories for cultivating microorganisms. The production process involves various methods, including ball milling mixing, spray drying, vacuum freeze-drying, and vacuum drying. Each method has its own advantages, and the choice of technique depends on the specific requirements of the cultur…
Introduction to Infusion Powders Used in Culture Media
News 9 10 月, 2024
Introduction Infusion powders are essential raw materials in microbiological culture media, widely used to promote the rapid growth and development of microorganisms. These powders are derived from plant or animal tissues through a series of processes, including soaking, heating, pH adjustment, filtration, and spray drying. Infusion powders are rich in …
Understanding Initial Contamination Bacteria: Detection and Importance
News 9 10 月, 2024
Initial contamination bacteria, or initial bioburden, refers to the microorganisms present on a product before sterilization. These bacteria originate from various contamination sources, including raw materials, manufacturing processes, environments, and packaging methods. The detection of initial contamination is crucial in determining the sterilization p…
Causes of Mold Contamination in Upright Incubation: Analysis and Solutions
News 9 10 月, 2024
Since the implementation of GB4789.15-2016 for mold and yeast counting, mold contamination during upright incubation has been a common issue for many labs. The method introduced in this standard, compared to the previous GB4789.15-2010, has led to concerns about environmental contamination, especially during upright incubation. This article will analyze th…
Common Microbial Culture Media and Their Performance Validation Using Standard Strains
News 8 10 月, 2024
In microbiology labs, it is essential to validate the performance of new or newly sourced culture media using standard strains before they can be used for testing. This ensures the culture media meet the required standards for microbial growth and testing. Here’s a detailed guide on commonly used microbial culture media, the standard strains used…
Understanding Water Activity in Food and Its Impact on Microbial Contamination
News 8 10 月, 2024
Microbial growth and toxin production in food depend on various factors, including temperature, nutrients, pH, and water activity (Aw). Water activity is particularly important in determining whether food is susceptible to microbial contamination. Most foodborne microorganisms thrive in environments with high water activity, where they grow quickly and rob…
Wrapping Up a Successful ARABLAB LIVE 2024: HuanKai Group’s Participation and Highlights
News 8 10 月, 2024
October 2024 – The HuanKai Group has just returned from the dynamic ARABLAB LIVE 2024 exhibition, held at the Dubai World Trade Centre from September 24-26. As one of the world’s leading events in the laboratory and scientific industries, ARABLAB LIVE provided a unique opportunity to showcase our latest innovations in microbiology, microbial detection…
A Detailed Introduction to the Spread Plate Method for Dilution (Principle and Steps)
News 8 10 月, 2024
The spread plate method is a common microbiological technique used for isolating, purifying, and counting microorganisms. Here’s a detailed guide on the principles and step-by-step procedure for performing this method. Principle of the Spread Plate Method The fundamental principle of the spread plate method involves diluting a microbial suspension an…
Microwave-Resistant Microorganisms: Unexpected Applications
News 30 9 月, 2024
Microwave ovens have become a kitchen essential, using electromagnetic waves to heat food by causing water molecules to vibrate and generate heat. This process effectively kills many bacteria, viruses, and parasites. However, a recent study has revealed the presence of various microbes inside microwaves, primarily from the Proteobacteria, Firmicutes, Actin…
About Microbial Culture Media: Top 10 Questions and Answers
News 30 9 月, 2024
Culture media form the foundation of microbial testing and are a key component in microbiology laboratories. However, questions often arise regarding their selection, storage, preparation, sterilization, and handling of expired media. This article addresses the top 10 questions about microbial culture media. 1. How to Select Microbial Culture Media…
Using Portable Glucose Meters for Precise Pathogen Detection in Food
News 30 9 月, 2024
Staphylococcus aureus is one of the most common foodborne pathogenic bacteria, known to cause various diseases. Recently, researchers have developed a sensitive and highly selective biosensor based on a personal glucose meter (PGM) platform to detect Staphylococcus aureus in food. Why Use a Personal Glucose Meter (PGM) for Bacteria Detect…
What is Pseudomonas Aeruginosa? Preservation Methods Explained
News 30 9 月, 2024
1. What is Pseudomonas Aeruginosa? Pseudomonas aeruginosa, previously known as Bacillus pyocyaneus, is a widespread bacterium found in nature. It is one of the most common bacteria in soil and can be present in various environments, such as water, air, human skin, respiratory tracts, and intestines. This bacterium thrives in moist conditions and is…